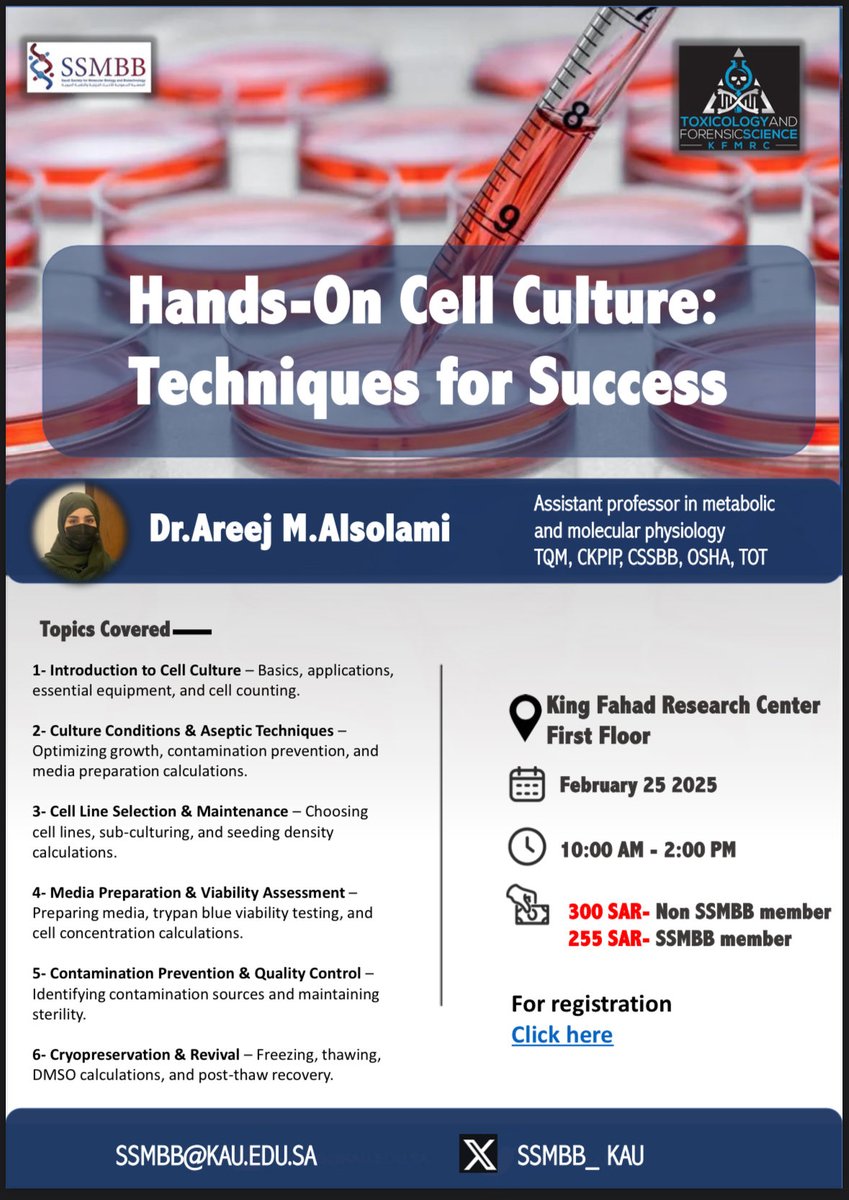

Rami obaid
@abolayan77
Rami Obaid, PhD - Assistant Professor at Umm Al-Qura University - College of Medicine in Al-Qunfudah - Medical Geneticist
[email protected]
ID: 337069767
17-07-2011 11:55:58
228 Tweet
204 Takipçi
397 Takip Edilen







لا يفوتكم "ملتقى الابتكار" معتمد ب ٦ ساعات من هيئة التخصصات الصحية!! ويضم نخبة مميزة من علماء الوطن 🇸🇦 الحاصلين على العديد من براءات الاختراع. شاركوا معنا لنستفيد من خبراتهم وتجاربهم بدايةً من استحداث الفكرة الى الحصول على البراءة والمزيد من المعلومات القيمة @kauweb ِ وزارة الصحة السعودية











يسر الجمعية السعودية للأحياء الجزيئية والتقنية الحيوية أن تعلن عن إقامة دورة عملية تدريبية عن أسس زراعة الخلايا تقدمها سعادة د. أريج السلمي د. أريج السُلمي خصم خاص لأعضاء الجمعية بقيمة ١٥٪ المقاعد محدودة سارعوا بالتسجيل. رابط التسجيل docs.google.com/forms/d/1uktUa…